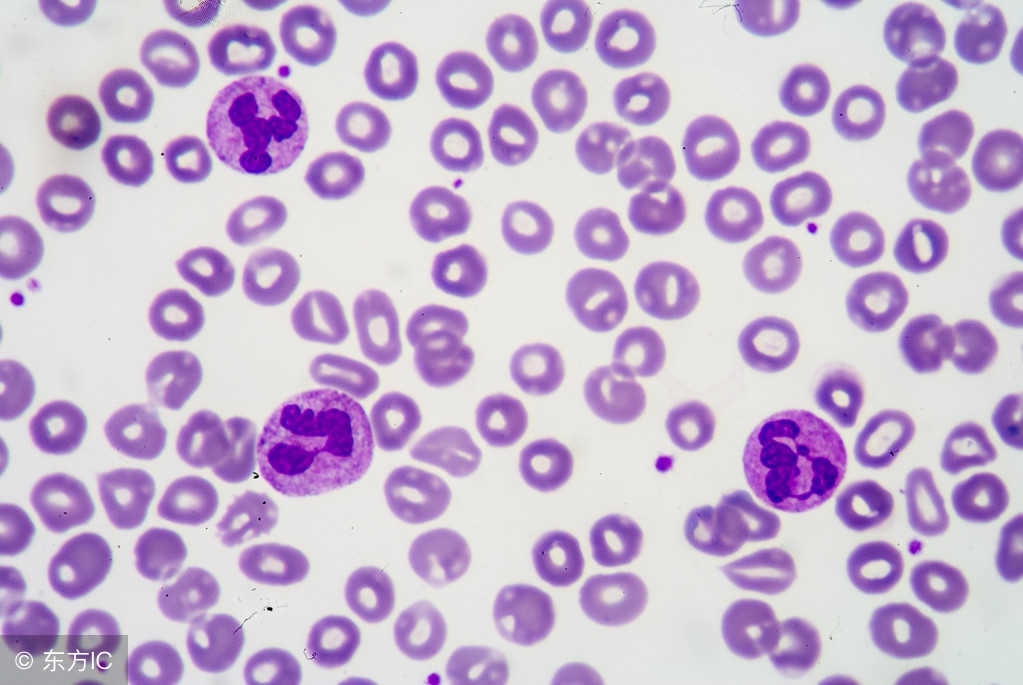
化疗导致白细胞低吃什么食物好呢,化疗期间白细胞低吃什么食物好

在医院候诊的时候,几个患者唠嗑,一个小媳妇八次化疗完事了,一个大妈是第七个疗程。俩人状态都挺好,都挺积极乐观的。小媳妇化疗不掉白细胞,反应也不大,身体基础真好。大妈说,能化疗能手术,都没问题。大妈还说了一个案例,有个农村的,自己摸出来胸口有硬块了,因为家里好几百只牛羊猪的,一直忙来着,等忙完了来医院,医生说来晚了,已经大面积扩散了,不化疗还能维持一段日子,一化疗身体影响太大,也就20天吧。家属选择化疗试试,结果真是二十来天人走了。在医院,真是好例子和悲伤的故事天天传播啊。化疗白细胞低吃什么生的最快?化疗中白细胞低吃什么比较好?吃什么食物有助于病人白细胞数量的提升?

癌症患者饮食应该以高营养、高蛋白质为主。由于化疗对肿瘤患者的副作用较大,可先由流食到半流食再到正常饮食的过渡。在一般的情况下,当外来细胞外入侵时白细胞的数量会升高,这是生命机体的正常反应,表明身体正在调动免疫系统调节来进行防御外来病毒细胞的侵害。如果体内白细胞数量太低,人体就会就会失去正常的“防线”控制,无法抵抗外界致病的因子毒素,容易造成感染。
白细胞太低情况严重,部分病人还会出现虚弱、食欲不振、疲乏、头晕、低热、慢性腹泻和口腔溃疡等表现。有时甚至会暂停化疗疗程,待病人白细胞数量回归正常水平才可继续治疗。嗅觉异常者和恶心呕吐者可在食物中加姜汁或喝些陈皮茶,也可以配合服用维生素B6和人参皂苷rg3。鼓励病人多进食,以营养丰富、清淡易消化的食品为好。应调动患者的视觉、嗅觉已增加饮食,调配平时喜爱的食物,少食多餐。
化疗过程中饮食注意:
注意多吃蛋白质含量高的食物,补充足够的蛋白质,加强营养,提高白细胞的数量。比如鸡、鸭、鸡蛋、鱼肉等,多喝牛奶、豆浆,多吃奶制品和豆制品,有助于白细胞的生成。宜采用煮、炖、蒸等方式烹饪,还可选择含铁元素较多的食物如动物肝脏、内脏、蛋黄以及菠菜、芹菜和番茄等。多吃新鲜的蔬菜和水果,可以选择桃、红枣、菠萝、李子、杏、葡萄干、杨梅和橙子等。

化疗过程中饮食禁忌:
不吃生葱蒜等重口味刺激性的食物、不吃高温烧烤、煎炒、油腻、烟熏和腌制和发霉等食物。宜吃牡蛎、海带、海藻、芦笋、紫菜、芹菜等具有清淡降火的食物。少吃发热、高脂肪的食物,比如兔肉、狗肉等。菜谱烹调忌多油、多盐,注意清淡。
除了饮食上的注意,也可以根据患者的实际情况选择中草药制剂来改善化疗后的副作用反应包括白细胞数量降低等。中西医结合治疗,在达到扶正固本的同时还能协同放化疗,增效解毒,增强自身免疫力,比如黄芪、人参皂苷rg3。
除了吃以外,肿瘤病人的心态也是非常重要的,从心理上克服障碍。积极配合治疗,坦然面对放化疗的副作用反应,做到心理和身理的相互调理。
由于化疗药物有一定的毒副作用,对身体的正常组织细胞也有*伤杀**效果的,频繁使用身体会承受不了的。并且癌细胞也有生长周期的,需要在癌细胞的分裂时期化疗,效果才最好的,所以需要间隔一段时间才能再次化疗的。一般定21天为一个周期。
放化疗后很多患者会出现食欲不振、恶心呕吐等副作用,此时服用中药对副作用的改善是非常好的,这一点在国际上都是被认可的,“如果是体质较弱的患者,在放化疗或手术前就开始服用中药,还能提高他的耐受性,帮助他按时、顺利地完成西医治疗。另外,中医药还可以缓解肿瘤患者的疼痛、水肿等很多症状。总之中医的目标就是协助西医让肿瘤患者活得更长,生存质量更好”。比较常用的中药人参皂苷rg3是从人参中提取的一种单体成分,人参具有大补元气、固脱生津之功,是古往来治疗虚证之要药,能补阳中之阴、阴中之阳,补益脾胃,益气补血,减少化疗毒副作用。